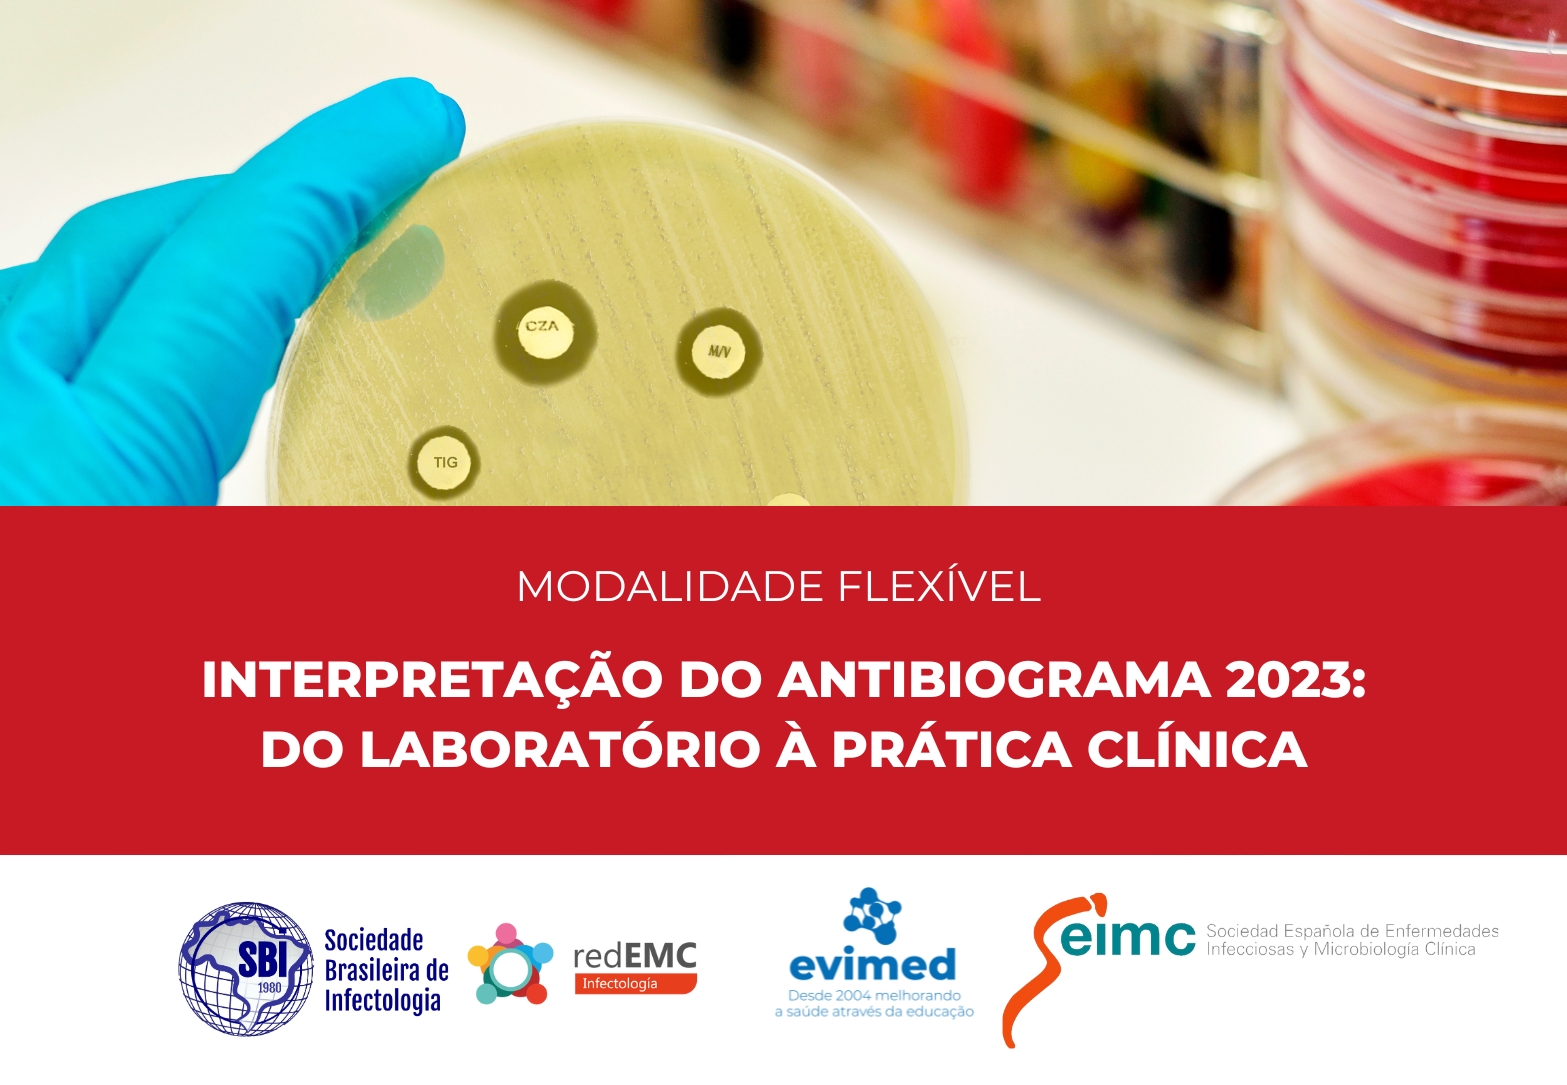

Menu
50
+
CURSOS REALIZADOS
10000
+
CURSANTES
100
+
DOCENTES
1
+
PAÍSES
10
+
INSTITUIÇÕES
Cursos on-line
de educação médica continuada
- Todos
- Infectologia
Por que escolher redEMC?
Somos a maior comunidade de profissionais da saúde da América Latina

ON-LINE
Cursos totalmente on-line e com liberdade de horários, adaptados aos tempos do cursante, de curta duração e com alto impacto na prática clínica diária.
multi idiomas
Cursos em español, português e inglês; com tradução em todos os materiais acadêmicos e eventos ao vivo, para uma aprendizagem integral.
INTERATIVO
Conectamos comunidades de profissionais de toda a Ibero-América, através dos fóruns de discussão e os eventos ao vivo.
DIDÁTICO
Materiais didáticos e práticos, exclusivamente desenhados pelos nossos profissionais para cada curso.
CERTIFICADO
Certificados com link verificável e respaldo das instituições organizadoras de cada atividade.
redEMC live
EVENTOS AO VIVO GRATUITOS!
Previous
Next
Cursos que inspiram mudanças!
Foi um curso com temas pertinentes à prática diária, com compartilhamento do conhecimento de maneira objetiva. Os casos foram essenciais para ajudar a ancorar o conhecimento adquirido. Parabéns a todos os envolvidos na criação e manutenção do curso.
William Jimbo OdaniAtualização em Medicina Intensiva com a Cleveland Clinic 2022
Excelentes paletras, vasto conhecimento dos tutores. Nos proporcionou ótimas oportunidades sobre o tema resistências, que muda sempre. Muito obrigado aos palestrantes por esta oportunidade e aos colegas. Grande abraço.
Eliza Maria Catellan ZandonadiInfecções Hospitalares e Resistência Antimicrobiana. 2022
Excelente curso!!! Excelentes explicações dos tutores. Farei novamente em uma outra oportunidade.
Lucianna Auxi CostaInterpretação do antibiograma na prática clínica diária. 2016
"Minhas impressões sobre o curso são as melhores possíveis . Os docentes mostraram muito conhecimento , foram didáticos e nos possibilitaram participar de casos clínicos."
Maria Raquel dos Anjos Silva GuimarãesInfecções Hospitalares e Resistência Antimicrobiana. 2022
Foi um grande prazer.
Muito agradecido pelo curso.
Realmente transformador. Grato.
Briner Castelli AzevedoInfecções Hospitalares e Resistência Antimicrobiana. 2022
Curso maravilhoso, passou muito rápido. É o segundo que faço,
já ansioso por mais.
Zilfran Carneiro TeixeiraAtualização em Medicina Intensiva com a Cleveland Clinic. 2022
Curso bem elaborado. Temas claros, Material didático muito prático.
Eduardo Luiz Pereira CostaDoenças Glomerulares. 2019
Foi muito gratificante e enriquecedor participar dessa metodologia de aprendizado.
Alba Regina Jorge BrandãoResolução de casos clínicos frequentes na consulta nefrológica, 2019 Evimed é a empresa líder que nucleia redEMC e suas diversas especialidades médicas. Nos especializamos em soluções e-learning em educação médica continuada com impacto na prática clínica. Oferecemos serviços institucionais adaptados a cada Sócio Acadêmico, desenvolvendo e implementando congressos e eventos de primeiro nível internacional. Em breve teremos novidades sobre os cursos 2023!
Somos redEMC!
Somos a empresa líder na América Latina dedicada à educação médica continuada com impacto na prática clínica.
Contamos com uma qualificada equipe multidisciplinária, composta por profissionais da área pedagógica, médica, tecnológica, da comunicação e marketing digital, com ampla experiência na temática da educação médica continuada e fortes vínculos universitários.
Trabalhamos de forma conjunta com importantes sociedades científicas da região e unimos laços com sociedades internacionais para oferecer cursos de atualização médica com impacto na prática clínica diária.
- Infectologia & Microbiologia
- Nefrologia
- Anestesiologia
- Medicina Intensiva
- Emergência
- Pediatria
- Obstetrícia
- Medicina do Esporte
- Gastroenterologia
Os cursos são ditados em espanhol, português e/ou inglés; todos com tradução no idioma correspondente. Este diferencial permite que o cursante expanda suas redes e conheça diferentes realidades e cenários sem limitação de idioma.
Estabelecemos importantes laços acadêmicos entre diversos sócios de toda a região, através do compromisso e excelência. Se quiser formar parte dos Sócios Acadêmicos, convidamos você a escrever para administracion@evimed.net contando sobre sua proposta educativa e com prazer, lhe daremos nosso feedback.
Na redEMC sempre estamos procurando novos talentos que queiram desenvolver seu potencial trabalhando tanto para o mercado local, como internacional. Se você quiser formar parte de uma equipe responsável, pró ativa e comprometida com um excelente ambiente de trabalho, lhe convidamos a enviar seu currículum vitae a administracion@evimed.net
Em caso de dúvidas, escreva para cursos@evimed.net

